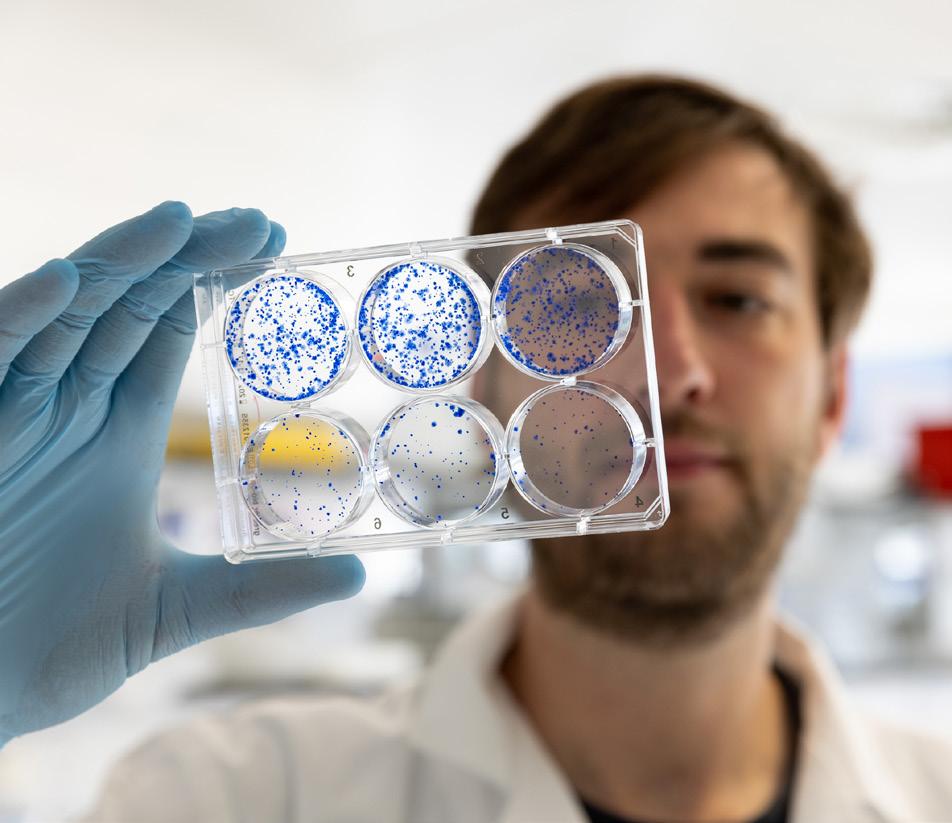

2023-24
Cork University Foundation advances the strategic goals and objectives of University College Cork and the foundation’s primary function is to generate financial support for the university’s agreed priorities.
Photography: Copyright UCC.





2023-24
Cork University Foundation advances the strategic goals and objectives of University College Cork and the foundation’s primary function is to generate financial support for the university’s agreed priorities.
Photography: Copyright UCC.


I want to extend my heartfelt gratitude to you, our donors, supporters and friends, who empower us to educate, innovate, and inspire.
In December 2025 we will mark 180 years since UCC, known then as Queen’s College Cork, was established. As we embark on our 180th year, it is a time to reflect on our history, to celebrate the achievements of our students, staff and alumni; and to look to our future as we reaffirm our commitment to a sustainable future for our people, planet and university.
Today UCC stands proudly among the top 1% of universities globally, the fourth most sustainable university in the world in the UI GreenMetric World University Rankings.
Today UCC adds €1.18 billion to the economy every year (that’s €3.2 million a day), while furthering education, discovery and societal advancement. We support 21,000 jobs in Cork City and county, and deliver a sixfold return on state investment.
“
Beyond accolades, our real measure of success lies in the lives we touch, the students we educate, the discoveries we pioneer, and the communities we serve.
Today UCC attracts over 25,000 students from 126 different countries and our graduates are in demand nationally and internationally. UCC is first in Ireland for graduate employability, and we remain committed to supporting students from diverse backgrounds with diverse talents.
Beyond accolades, our real measure of success lies in the lives we touch, the students we educate, the discoveries we pioneer, and the communities we serve. Education is significantly underfunded by the state and it’s your support that fuels opportunities — scholarships that change lives, research that transforms industries, and initiatives that strengthen our community.
For 180 years philanthropy has enabled the university to seek new ways to solve problems, to enhance the environment we live in and to offer opportunities to some of the top academics in the world. As we look to the future, your partnership will be more vital than ever as we work to create lasting positive change. Thank you for believing in our mission and for being part of this incredible journey.

Professor John O’Halloran President, UCC

“
Achieving truly impactful results requires the dedication and hard work of many people, not least Cork University Foundation Board members and the team in UCC’s Advancement Office. Thank you — together, we are creating a lasting legacy for future generations.
”
Professor John O’Halloran President, UCC

On behalf of the Cork University Foundation Board, I am delighted to introduce this year’s Philanthropy Impact Report.
This publication showcases the extraordinary impact that your support has enabled through research, scholarships, student experiences, and more - impact that simply would not be possible without the generosity of our community.
Funds were received in support of research into Crohn’s disease, cancer research, and children’s rights. The Cerebral Palsy Foundation partnership with INFANT was noteworthy as it secured matched funding from the SFI Strategic Partnership Programme. There were also significant new gifts for research into the microbiome to better understand how anxiety, cancer, autism and Parkinson’s disease are all related to the gut.
“ This publication showcases the extraordinary impact that your support has enabled ”
Philanthropy is funding projects aligned to student success including the UCC Graduate Attributes Programme and scholarships to support entrepreneurs, women in STEM and postgraduate students. Another powerful example of impact from the ACCESS programme is the Removing Barriers: Building Futures story where Brian Votta highlights how philanthropy is breaking down barriers to education. Thanks to the generosity of the late Dr Mary Barry Wall, Brian has been able to pursue his dream of becoming a teacher. His journey underscores the importance of removing financial obstacles so that aspiring educators from all backgrounds can thrive.
A crucial part of Ireland’s hidden heritage are the hundreds of handmade manuscripts written in Irish that have survived from medieval to modern times. New multi-spectral imaging equipment and the employment of two postgraduate students will enable the work of image-capture and analysis. The Book of Lismore, showcased in the 2020/21 Philanthropy Impact Report, is the first manuscript to be analysed using the new equipment. Internationally renowned Professor of Modern Irish, Pádraig Ó Macháin explains how we are getting a new perspective on how these manuscripts were made and the craftmanship involved, and already new previously hidden signatures have been revealed on the ancient parchment.
Thank you for your continued support.

Neil O’Leary Chair, Cork University Foundation

Since its establishment in 1996, Cork University Foundation has assisted the university with its fundraising activities, helping maintain it as an internationally recognised university through the implementation of its strategic plan and the quality of its student experience, including excellence in teaching, learning and research.

As Cork University Foundation approaches its 30th birthday, the board and the Advancement Office (formerly Alumni and Development) have been reflecting on the critical importance that philanthropy has played in the UCC ecosystem over the decades. From the Glucksman Gallery, the Mardyke Sports Arena, the Honan Chapel, the Brookfield Medical Campus, the Student Calm Zone, to numerous academic positions and cultural acquisitions, the Atlas publication series, student scholarships, prizes, student projects and more.
2023-2024 was a year of steady progress and resilience - raising almost €13m in new commitments from philanthropic trusts, donor advised funds, company giving and individuals. Over 170 alumni and friends responded to our first #GivingTuesday appeal; and the UCC Alumni Fund was able to support areas of urgent need, including support of PAWS, a well-being initiative bringing therapy dogs to campus.
Every contribution, no matter the form, creates a ripple effect, strengthens our university’s mission and helps shape a better future.
In just a few years we have trebled our donor base and, secured almost €43m compared to €16m in the previous threeyear period. We are deeply thankful to our donors and friends. Education is underfunded and there are many calls on the philanthropy team. It is clear that fundraising must be better embedded into the life of the university and that we must prioritise our needs. We have engaged a leading Higher Education fundraising consultancy firm to undertake a feasibility study to help us focus where to concentrate our efforts.
A common dichotomy faced by our sector is balancing a resourceheavy engagement programme while also delivering return on investment. These two things need not be mutually exclusive as it is often thoughtful involvement that begets transformative investment. Philanthropic support, advocacy and volunteering support at every level is important.
Every contribution, no matter the form, creates a ripple effect, strengthens our university’s mission and helps shape a better future. Thank you.

Kerry Bryson CEO, Cork University Foundation

8,725 alumni took part in our alumni survey, sharing their preferred channels of communication, areas of interest, volunteering preferences and their readiness to make a gift. These insights informed the Stakeholder Engagement Plan which underpins our fundraising plans, supports a culture of philanthropy and volunteering and reimagines our approach to communications and events.
The donor roll of honour recognises individuals, companies, foundations and trusts, who have supported UCC during the financial year, 1 October 2023 to 30 September 2024.
We would like to thank our 22 anonymous donors, those who have told us that they intend to leave the university a gift in their will, and those who volunteer their time to help the university in a number of different ways.
Thank you also to donors who contributed to Cancer Research @UCC through a variety of community fundraising events.
We very much appreciate your generosity and your support of the university’s mission.
Every effort has been made to ensure this donor list is correct. If you think there is an error please contact foundation@ucc.ie
Aaron S Doherty
Abbott Ireland
Adrian Lapuste
Adrian M Greaney
Adrienne M Kennedy
Aengus Hallinan
Agricultural Trust
Ahmad I Muhamad
AIB Credit Card Services
Aideen H Hogan
Aindrias T Wall
Aine B Foley
Akeem F Gbemisola
Alan D Deasy
Alan J O’Driscoll
Alan M Sheehan
Alan P Goulding
Alanis Capital
Alexandria O Brien
Alison H Perrott
Alison M Taylor
ALK-Abelló
Andrea C O’Brien
Andrea L Bickerdike
Andrew G Keating
Andrew J O’Callaghan
Ang Gao
Angelina E Espinoza-Limon
Anne M Corcoran
Anne M McAuliffe
Anne M Murphy
Anne M O’Mahony
Ann-Marie O’Sullivan
Anthony Barry
Anthony G Coughlan
Anthony J Duffy
Anthony Muldoon
Aoife B Moriarty
Aoife C Granville
Aoife C Luttrell
Aoife M O’Sullivan
Aoife P Kiely
Apple
Arjun Nair
Arlene L Gibbons
Arthur C O’Keeffe
Arthur Cox
Arup Charitable Trust of Ireland
Augustine P O’Keeffe
Babatunde Olotu Jubril
Bairbre Higgins
Barry’s Tea Ltd
Bartholomew D Murphy
Bebhinn M Coghlan
Benjamin M Williamson
Bernard O’Donovan
Bird Control Ireland Ltd.
Bjorn Haug
Boston Scientific
Breakthrough Cancer Research
Breda O’Mahony
Brendan A Mullins
Brendan Hallahan
Brendan J Kelly
Brendan O’Sullivan
Brendan T O’Flaherty
Brian A Corcoran
Brian B McCarthy
Brian C Kerr
Brian D Shanahan
Brian D Twomey
Brian O’Driscoll
Bridgid M Galvin
Bryan T O’Sullivan
Cadence Design Systems
Caitlin J O’Leary
Caitriona B Ni Ealaithe
Caitriona M Keogan
Cal Healy
Caoimhe M Casey
Caren E Baviera-Betson
Carmel M Blake-Burke
Carmel M Shortiss
Carol M Duggan
Carol N Walsh
Caroline M Burke
Caroline M McGarry
Catherine Field
Catherine Keohane
Catherine Maria O’Shea
Catherine T Cronin
Cerebral Palsy Foundation
Charles W Ardley
Chris Williams, RIP
Christine A Shinkwin
Christine M Harris
Christopher O Page
Cian M Kiely
Ciara C McGlade
Ciara E O’Sullivan
Cloyne Pharmacy Ltd
Colin B Ross
Colm A O’Rourke
Community Foundation Ireland
Conor J Cashman
Conor J Crowley
Conor Jeffery
Conor M Lehane
Conor M Twomey
Cork Grassland Services
Cormac P Sweeney
Cornelius F O’Connell
Cornelius M O’Sullivan
Noel Mar Leonard
Cure CMD
Dairy Industry Ireland
Dairygold Co-op Ltd
Daithi S O Rian
Damien P Reidy
Dan Kelleher
Daniel F Harte
Daniel G Coffey
Daniel J Lehane
Daniel J Troy
Daniel M Crowley
Daniel M Kearney
Daniel M Leahy
Daniel M O’Sullivan
Daniel Martin Murphy
Daniel S Nelligan
Daniel S O’Neill
Daniel V Fenton
Danielle D Lawlee
Dara Hanamy
Daragh and Anne Horgan
Darragh O’Sullivan
David A Nation
David Hogan
David J Fleming
David J Ronayne
David M Giltinan
David M Slattery
David P Bennett
David T Cotter
Declan G Hegarty
Declan J Barry
Declan J O’Connell
Declan Kinahan
Declan M O’Brien
Deirdre A Murray
Deirdre E Murray
Deirdre M Byrnes
Deirdre Quinn
Deloitte
Denis F Hanley
Denis F O’Regan
Denis Flynn
Denis G Ryan
Denis N Daly
Denis P O’Regan
Derek P Dunne
Dervla Á Hogan
Devere Foundation, James P.
Diana P Byrne
Diane McIntyre
Diarmuid A Kilcullen
Diarmuid O’Donovan
Donal G O’Sullivan
Donal Holland
Donal P Sheehan
Douglas S Murray
Eadaoin C Hayes
Éamonn A Ó Carragáin, RIP
Eamonn O’Shea
Eanna J Martin
Eddie O’Shea
Edel Rigas
Edmond J Murphy
Edmund D Enright
Edward C Cogan
Edward J Fitzgerald
Edward J Murphy
Edward W De Barbieri
Elaine M Dee
Elizabeth A Fitzsimons
Elizabeth A Gould
Elizabeth A Phelan
Elizabeth A Roper
Elizabeth C Murphy
Elizabeth M Dooley
Elizabeth M O Gorman
Emer Mary Foley
Emer P O’Connell
Emma E Denning
Eoghain G Murphy
Eóin Mac Domhnaill
Eoin O Luasa
Eoin T Murphy
Erica S Bettin
ESB Group
Eugene N Clarke
Evelyn A Galbraith
FBD Holdings plc
FDC Group
Fergus E Daly
Fergus V Coakley
Fexco
Finbarr D Murphy
Finbarr J O’Driscoll
Finbarr J O’Mahony
Finbarr Michael Herlihy
Finola M Cooney
Finola Neville O’Donnell
Fiona E Russell
Fiona M Murphy
Flavio A Cali
Florence V O’Mahony
Fondation Botnar
Francis J O’Keeffe
Francis W Mulvihill
George D Shorten
Geraldine A Moynihan
Geraldine A Murphy
Geraldine B Boylan
Gerard F Barry
Gerard F Flaherty
Gerard P O’Hanlon
Gerard Ryan
Gillian M Power
Gillian M Williams
Gladys Ogedegbe
Grace J Ahern
G-Research
Gym + Coffee
Hannah T Glynn
Helen Ita Leahy
Helen M Boyle
Helen M Collins
Helen Mulcahy
Helen T Byrne
Helena Burns
Henry Gerard Hawney
Horner Automation Group
Hugh A Lee
Hyland Security Systems
Ina O’Sullivan
Institute of Geologists of Ireland
Irene M Ryan
Irish Cattle Breeding Federation
Ismahane Meliani
J & G MacCarthy
Jack A Murray
Jack R Kennedy
Jacqueline M Sheridan
James A Buckley
James A Macguill
James B Tuohy
James D’Arcy
James Dorney
James J O’Shea
James K Cadogan
James M Crotty
James M Murray
James McEntee
James Murphy
James N Cassin
James P Ryan
James T Moore
Jamie O’Sullivan
Janet M Kirwan
Janice M Crausaz
Janssen Pharmaceutical
Sciences
Janssen Sciences Ireland
Jean A Keating
Jean M O’Donovan
Charles J Sullivan
Charles P Daly
Eli Lilly Kinsale
Eliza Spakman
Jean Murray
Jennifer A Whyte
Jennifer D Mahony
Jennifer K Curtin
Jennifer M Kearney
Jennifer M O’Shea
Jennifer M Owens
Jessica Jones
Jill Powell
Jim Barry
Joan Hinton Hurd
Johanna F Hyland
John A Blackwell
John A Keane
John A McEvoy
John A Murphy
John A O’Donovan
John B McElligott
John B Rose
John C O’Connell
John C O’Sullivan
John C Riordan
John Curtin
John D Riordan
John D Sheehy
John E O’Connell
John F Murphy
John F Whelan
John G Boylan
John G Doherty
John G Kiely
John G MacCarthy
John G O’Malley
John Grogan
John J Desmond
John J Field
John J Fitzgerald
John J Jefferies
John J Roche
John M Feerick
John M O’Regan
John O’Callaghan
John O’Dwyer, RIP
John O’Halloran
John P Brennan
John P Connolly
John P Curtin
John P O’Connell
John P O’Donoghue
John P O’Gorman
John T Browne
John T OConnor
John W Murphy
Jonathan P Olden
Josef & Anni Albers Foundation
Joseph A Jordan
Joseph O’Dwyer
Joseph P McDonnell
Josephine M Kelleher
Josephine N Ahern Loftus
Julia C Healy
June P O’Connell
Justin D Barry
Kantikiran Dasari
Karen Barry
Karen M Tyrrell
Karen N McCarthy
Karen S Kelly
Kathleen M Ronayne
Kathy Dowling
Keith J Moran
Kenneth A Walsh
Kerry Bryson
Kerry Group Plc
Kevin D O’Driscoll
Kevin J Murphy
Kevin J O’Donovan
Kian Mintz-Woo
Kieran Fitzgibbon
Kieran McCormack
Kieran T Morrison
Koteswar Kareti
KPMG
Laila O’Keeffe
Laura H FitzGerald
Laura Sahm
Laurna K McGovern
Lekha Menon Margassery
Leslie and Eileen Quick
Liam A Jennings
Liam M Harte
Linda J Sparks
Lingzi Zhou
Lisa M Mellerick
Logitech
Lorraine A O’Donovan
Louise M Ni Mhuircheartaigh
Lucy U Scally
Maeve M Collins
Margaret M O’Connor
Margaret R Creedon
Marguerite M Ahern
Maria A Dunne
Maria B Browne
Maria C Walsh
Maria C Warren
Maria D Kelly
Marie B O’Sullivan
Marie C Russell
Marie S O’Donnell
Marie-Claire O Dwyer
Marietta Landers
Marigot Ltd
Mark Clancy
Mark Cooper
Mark Eugene O’Driscoll
Mark F Collins
Mark F O’Brien
Mark J O’Connor
Martha M MacPhiarais
Martin B Studdert
Mary A McCullagh
Mary E Conway
Mary E Shorten
Mary F Fitzgerald
Mary Lavery
Mary M Devlin
Mary McCarthy
Mary P Higgins
Mary P O Callaghan
Mary T Kelleher
Mary T Lombard
Matthew M Collins
Maureen McCann
Maurice A Fahy
Maurice J O’Donoghue
McCann Fitzgerald LLP
Michael A Bouchier
Michael B Morrissey
Michael C MacNamara
Michael Dolan
Michael F Shanahan
Michael G Cahill
Michael G Hoctor
Michael G Jackson
Michael G Molloy
Michael G Murphy
Michael J Dowling
Michael J Duggan
Michael J Mackey
Michael J Walsh
Michael J Willis
Michael Lyons
Michael M Bennett
Michael Martin McCarthy
Michael N Wilkinson
Michael P Griffin
Michael P McGarry
Michael P Mortell
Michael Shanahan
Micheal E O’Shea
Michelle Clifford
Morgan Buckley
MSD
Muiris T Kennedy
Myles Gallagher
Navya Melam
Nederlandse Zuivel Organisatie
NetApp
Niall Cavanagh
Niall G Cotter
Niall Gillis
Niall P Looney
Niall P Sheehan
Niamh M Mulligan
Noel Furlong
Noel M Leonard
Noel J Tangney
Noelle A Barry
Noelle T Dowling
Nora M Goggin
Noreen A Walsh
Noreen M O Flynn
Norleen M O’Sullivan
Norrie Walsh
Novartis Ringaskiddy Ltd
Oonagh I Breen
Oonagh Mary O’Driscoll
Orla M Cotter
Orla M Flynn
Orla M O Carroll
Owen F O’Neill
Padraig M Lucey
Patricia Desmond
Patricia O’Donovan
Patrick G Ryan
Patrick J Donohoe
Patrick J Kennedy
Patrick J Shanahan
Patrick J. J Quinn
Patrick T O’Connor
Patrick T Walsh
Paul Fitzsimons
Paul G Tuohy
Paul K Geaney
Paul Keyes
Paula M O’Callaghan
Paulie Rainbow
Peter C Blake-Burke
Peter D Moriarty
Peter Fleming
Terence J McSwiney
Tessa T Neville Gaynor
The James & Veronica
Chesterton
Family Foundation
The Leona M & Harry B Helmsley
Charitable Trust
The Liffey Trust
The Lifford Trust
Theresa Wilson
Thia Hennessy
Thomas D McKenna
Thomas F Hinchy
Thomas G Wrixon
Thomas J Kenny
Thomas K Bambury
Thomas K Murray
Thomas M Kelleher
Thomas M Moloney
Timothy Corcoran
Timothy J Coffey
Peter G Rolls
Peter J Connolly
Peter J Lynch
Philip G Corrigan
Philip H Bredin
Philip T O’Loughlin
Phillip P Gostelow
Provest Private Clients Ltd
Qualcomm
Rachel M Liston
Rathaspek Golf Club
Regina Fitzpatrick
Rene Radusky
Renee C Swift
Richard E Foley
Richard J Halpin
Richard Tanner
Richard W Flannery
Risteard J MacPhiarais
Rita Kelly
Ritchie Mooney
Robert A Toner, RIP
Robert T O’Leary
Roberto Trevino
Roisin E O’Sullivan
Roisin Ni She
Ronan Buckley
Ronan O’Shea
Rosalie M Ní Mhaoldomhnaigh
Rosanna V O’Keeffe
Roy M Geary
Ruth A Delaney
Ruth Cotter
Ruth Davis
Sabina Tabirca
Saint Finnian’s Trust
Saks Kavanaugh
Samantha M Lambert
Sandra M Hanrahan
Sarah A Coveney
Sarah J Clifford
Sarah M Hayden
Sarah M Murphy
Saranna Fanning
Schubert Soares
Seamus M Boyle
Sean A Kiely
Seán Freaney
Sean M O’Brien
Sean O McCarthy
Sean T Carey
Seán T O’Shea
Shane M O’Neill
Sharon P Keohane
Shona R Meagher
Simon J O’Keeffe
Sinead M Murphy
Sinead M O’Donovan
Siobhan C O’Connell
Siobhan Kangataran
Siobhan McCarthy
Southern Law Association
Southern Milling Ltd
Statkraft
Stephen J O Brien
Stephen J O’Shaughnessy
Stephen Moylan
Susan F Harvey
Susan Mary Patricia Curtin
Synapse Medical
Tamara H Wanigasekera
Tara M O’Carroll
Teagasc
Timothy J Crowley
Timothy K Coakley
Timothy M Geaney
Tom P Mannix
Tom Quick
TOMAR Trust
Tomas Clancy
Una M Murphy
UPMC
Ursula Kilkelly
Viv Maher
Vivien A Fitzgerald-Smith
Weston Family Foundation
WHH Foundation
William C Kennedy
William Crone
William Davitt
William J Beckett
William J Moore
William Kearney
William N & Bernice E
Bumpus Foundation
William O Kirwan, RIP
William O’Brien
Xue Li
Zisis Sakellaris
UCC and Cork University Foundation thank you for your most generous support in 2023-24
• €12.96m in new gifts and new commitments
New Assets
• Installation of the UCC Remembrance Bench
• Launch of the Cavanagh Way walkway



Highlights



UCC Futures
€8.9m

Including 357 new donors giving for the first time

Arts & Culture
€200k


UCC Alumni Fund
€67k
Student Experience
€2.8m
Sustainable Futures
€50k

8725 alumni survey responses

Early detection and intervention make a significant difference in the long-term outcomes and quality of life for people living with Cerebral Palsy (CP).
ELEVATE is a new €11.6 million research programme which brings together a team of researchers and experts in early brain injury to create cutting-edge AI screening algorithms to detect CP early, devise novel detection methods, explore potential new treatments, and actively involve CP-affected families in ongoing trials, education, and information platforms.
CP is the most common childhood-acquired, lifelong physical disability, affecting about 17 million people worldwide. It is caused by abnormal development or damage to the brain before, during, or shortly after birth. Many individuals with CP face significant and unnecessary challenges in their daily lives, including problems with movement, speech, and other body systems. An estimated 12,500 people in Ireland are living with CP.
The Cerebral Palsy Foundation has provided support of over €5 million, through Cork University Foundation, with the balance funded by the Science Foundation Ireland Strategic Partnership Programme. Led by the Irish Centre
for Maternal and Child Health Research (INFANT) at UCC, the programme will partner with RCSI University of Medicine and Health Sciences, TCD and all the tertiary-level maternity hospitals in Ireland.
“The ELEVATE team shares a vision of creating meaningful change in the lives of individuals living with Cerebral Palsy as well as their families. This partnership will be a game changer for the prevention, diagnosis and treatment of Cerebral Palsy in Ireland.
Rachel Byrne Executive Director of the Cerebral Palsy Foundation


A generous philanthropic gift from Brian McCarthy and Fexco is supporting groundbreaking research at UCC; science is being applied for the first time to uncover obscured text, signatures and hidden writing features in medieval Irish manuscripts, including The Book of Lismore.
The donation funds state-of-the-art multi-spectral imaging (MSI) equipment, which will use infrared and ultra-violet analysis to uncover previously obscured text and marks in ancient manuscripts. This groundbreaking technology will create detailed images, shedding new light on Ireland’s rich literary heritage.
Led by Professor of Modern Irish, Pádraig Ó Macháin, this initiative builds on the Inks & Skins project, which has already uncovered lost texts in manuscripts such as the Book of Uí Mhaine and the Stowe Missal. Now, with the establishment of the McCarthy Multi-Spectral Irish Manuscript Project (McCarthy MSI), UCC strengthens its position as a leader in medieval manuscript research. The donation also supports postgraduate students, ensuring the next generation of scholars can progress this important work.
The Book of Lismore, created in the late 15th century, is the first manuscript to be analysed under the McCarthy MSI project. Future collaborations with institutions such as the Library of Congress, the Royal Irish Academy Library, and the Dublin Institute for Advanced Studies
will expand this research, ensuring Ireland’s manuscript heritage continues to be explored and preserved for future generations.
Professor Ó Macháin believes that the handwritten book is central to understanding Gaelic society and that Brian McCarthy’s vision will drive new discoveries, scholar training, and global leadership in manuscript research.
“
This research will allow these books to speak for themselves for the first time, a debt of gratitude is owed to our scholarly ancestors for preserving our literature and traditions in these wonderful, unique books.
Professor Pádraig Ó Macháin Principal Investigator, Inks & Skins



In 2020, The Book of Lismore, created in the late 15th century, was donated by the Trustees of the Chatsworth Settlement to UCC. It contains some of medieval Irish literature’s greatest masterpieces, including the lives of Irish saints, the only surviving Irish translation of the travels of Marco Polo, and the adventures of the hero Fionn mac Cumhaill. Recent work has revealed signatures on The Book of Lismore for the first time.
For more than two decades APC Microbiome Ireland (APC), a Research Ireland Centre at UCC, has been a global leader in gut health and microbiome science, a new field of science that has transformed our understanding of human health and disease. APC’s work addresses major global challenges, including chronic disease, antimicrobial resistance, and sustainable food production.
APC has pioneered new fields such as the gutbrain-microbiome axis and has hugely advanced our understanding of the role of the microbiome in early life, elderly health, and inflammatory bowel disease. Researchers at APC have discovered thousands of microbes and novel anti-microbial peptides with the potential to treat life-threatening infections. APC has also spun out companies that are translating discoveries into real-world applications, with its researchers recognised among the most highly cited worldwide.
Beyond research, APC is committed to education, public outreach, and industry collaboration. Over the last 10 years, 250 PhD graduates have trained at the centre, with 42% of alumni securing positions in industry. More than 65,000 school children have engaged with APC’s science education initiatives, including walking through the APC’s specially designed inflatable gut
(pictured below), inspiring the next generation of researchers.
In October 2024, APC collaborated with UCC’s School of Microbiology to create the first Masters in Microbiome Science in Ireland to develop the next generation of global leaders and innovators in academia and industry.
As a key contributor to UCC’s Futures Programme, most notably the UCC Futures for Food, Microbiome and Health, APC plays a vital role in advancing research in alignment with institutional and global sustainability goals, providing tangible and impactful solutions to some of the most important global challenges of our time.
With the support of donors and partners, APC continues to mobilise the power of microbes for the benefit of human and planetary health, shaping the future of microbiome science.

“ Gut science has been the hottest area for the last decade or more. Anxiety, depression, cancer, autism, and Parkinson’s disease are all related to the gut. ”
Professor John
Cryan
Vice-President for Research and Innovation
who features in the Netflix documentary Hack Your Health: The Secrets of Your Gut

Cancer treatment can be challenging for men, with common complications such as weight gain, muscle loss, sleep disturbances, continence issues, and erectile dysfunction often left unaddressed in standard care. Many struggle to find the necessary support, leading to significant quality-of-life burdens.
For the first time in Ireland, a UCC-led clinical trial is integrating specialised survivorship support into hospital-based care. The Irish Cancer Society LIAM Mc Trial (Linking In with Advice and Supports for Men with Metastatic Cancer) is a €300,000-funded initiative designed to provide holistic care for men during and after cancer treatment.
The two-year pilot, based at Cork University Hospital’s state-of-the-art cardiac rehab gym, provides a structured 12-week programme featuring specialist nursing and dietitian support, twice-weekly physiotherapy, and access to social work and psychological services. In addition to routine oncology follow-up, participants undergo assessments at multiple stages, evaluating their physical function, fatigue, cardiovascular fitness, and overall quality of life.
Preliminary findings already highlight significant benefits for patients, including improved physical
well-being, stronger coping strategies, and an enhanced overall quality of life. With these promising results, there is hope that this model will set a new standard of care for male cancer patients across the country.
“
Participating in the LIAM Mc study not only benefits the men who partake, but will also help men in the future who are diagnosed with cancer.
Professor Jack Gleeson Principal Investigator, whose work as Associate Professor of Medical Oncology at UCC is funded by UPMC.

“
I had given up on exercising because I thought I couldn’t with my cancer, but I’m delighted to get back to it! ”
Trial Participant

“
I felt myself coming back, I found the old Frank I had lost. ”
Trial Participant
People like to support cancer research and it’s universities and research centers that find the answers. You can support cancer research directly by giving to the Cork University Foundation today.
The UCC Alumni Fund plays a vital role in enhancing student life, funding initiatives that enrich learning, well-being, and community engagement. Thanks to the generosity of alumni and friends, regular giving ensures that impactful projects, often beyond the scope of state funding, become a reality. Through regular giving and initiatives like #GivingTuesday, alumni continue to empower the next generation, proving that even small contributions create a lasting impact. Here are some examples.
#GivingTuesday is a worldwide movement of generosity, uniting thousands of charities to raise vital funds for meaningful causes. UCC’s 2023 appeal resulted in 174 alumni and supporters donating over €22,000 to support transformative projects across the university. Every donation directly benefits UCC students, creating lasting change on campus.
Student feedback highlighted the urgent need for more private study areas, prompting the UCC Alumni Fund to invest in three state-of-the-art Hush Pods in the Boole Library.
These ventilated, privacy-frosted pods, equipped with power outlets and adjustable lighting, provide a quiet space for focused study. They are also used for podcast recordings, online interviews, and peer support sessions, ensuring a multifunctional benefit to students across disciplines. Since their introduction occupancy has remained above 85%, proving their immense value.



University life can be overwhelming, especially for new students adjusting to a demanding academic environment. To address this, UCC partnered with My Canine Companion (MCC) to introduce PAWS @ UCC, a well-being initiative bringing therapy dogs to campus. Whether through library visits, community events, or one-on-one interactions, PAWS fosters emotional support and combats loneliness and stress. This programme, made possible in part through the UCC Alumni Fund, is paving the way for sustainable animalassisted well-being interventions in higher education.
“
Having
the dogs on campus has been a game-changer. They bring a sense of calm and joy to stressful days, and their presence makes UCC feel like home.
Maeve Barrett Student, BMus



The UCC Student Forum, modeled on the Irish Citizens’ Assembly, gives students a platform to shape university policy. Participants, representing a diverse range of backgrounds and university disciplines discuss key issues, propose solutions, and present recommendations to UCC’s Governing Body. This initiative, supported by the UCC Alumni Fund, ensures students play a central role in shaping their university experience. Discussions on making sports more inclusive led to a studentled referendum, securing student-paid investment
improved sports facilities.
At a special UCC event, scholarship recipients showcased how philanthropic support is driving their research and shaping their futures. From tech innovations to creative storytelling, medical breakthroughs, and entrepreneurship, these scholars are breaking new ground, thanks to the generosity of Cork University Foundation supporters.


Bob Jackson is a PhD Puttnam Scholar with UCC’s Film & Screen Media Department. His work focuses on creative practice and concerns the way we present historical stories on screen, focusing on the conflict which arises between recorded history, and the versions we see in documentary and drama.
The Puttnam Scholarship is open to all final-year undergraduate and postgraduate students UCC,

Shannen O’Reilly, founder of TrustDish, created a user-friendly app which allows individuals with food allergies and intolerances to dine out without stress, or embarrassment, enabling direct communication with food preparers. The app identifies safe food options at TrustDish Members’ establishments and connects directly with the kitchen for ultimate control and peace of mind.



Hugo Guenebaut, a computer science student, was selected as the first UCC recipient of the Dr Seamus McDermott Entrepreneurship Scholarship. This annual award, established by the Liffey Trust in honor of its founder, supports aspiring entrepreneurs in their academic and professional growth.
Hugo chose to study Computer Science at UCC because of his love for technology, electronics, 3D printing and computers. He believes that this scholarship will allow him to network with like-minded entrepreneurial students and with mentors who can encourage his future development.

Réré Ukponu is a Graduate Entry Medicine student with a passion for both science and the arts. As a Quercus Creative & Performing Arts Scholar, she balances the rigorous demands of medical training with her talents as a poet and short story writer, and her aspirations to become a novelist. Grateful for the financial support she receives through the scholarship, Réré values the encouragement and belief in her abilities, which allow her to pursue both her medical career and creative passions. “It’s all well and good to have faith in yourself but sometimes you do need somebody else to be like, ‘you’re good at this, we want to see you flourish’” she says.
The Quercus Talented Students’ Programme is supported by Bank of Ireland.
“ Bringing together our supporters and the students who have directly benefitted from their generosity highlights the profound impact these relationships have. Each gift not only shapes an individual’s future but also contributes to the growth and strength of the community we are building together.
Kerry Bryson CEO, Cork University Foundation

Philanthropy is driving global impact at UCC. From maternal health initiatives in Tanzania to groundbreaking Parkinson’s research and transformative study abroad experiences, donor generosity is supporting pioneering research and improving lives worldwide.
UCC’s global impact in food and health research is strengthened by an exciting partnership with the Dutch Dairy Association (NZO). Through their generous support, international dairy science leader Professor Thom Huppertz has joined UCC’s School of Food and Nutritional Sciences, enhancing research in Food, Microbiome, and Health.
This collaboration also funds a PhD student through the Cork University Foundation, fostering the next generation of dairy researchers. By bridging expertise between Ireland and the Netherlands, this partnership is driving innovation in dairy science with real-world benefits for nutrition and health worldwide.


Thanks to the Gerard Wrixon Research Excellence Travel Bursary, Tyndall PhD students are advancing groundbreaking medical technology on the global stage.
Daragh Crowley spent six months at Washington DC’s National Children’s Hospital, applying electromagnetic sensor research to surgical navigation and robotics. His work helps to bring wireless tracked sensors from lab to operating room and supports safer, more precise surgical interventions without the use of harmful radiation.
Saif Wakeel, as a Visiting Researcher at MIT, explored innovations in photonic integrated circuits and packaging. Donor support empowers researchers to collaborate with world leaders, driving real-world medical advancements.

Through the generosity of donors via the Cork University Foundation, UCC’s INFANT Research Centre is improving maternal and infant healthcare in Tanzania. In collaboration with the Kilimanjaro Clinical Research Institute, INFANT has developed a cloud-based birth registry at the Kilimanjaro Christian Medical Centre. This innovative system enhances data accessibility for researchers and healthcare providers, improving maternal and newborn health outcomes.
By training local staff and refining the registry based on local needs, INFANT ensures sustainable impact. This initiative exemplifies how philanthropy helps UCC bring life-changing medical advancements to regions where they are needed most.


Donor funding has strengthened UCC’s global reach by supporting the annual Fulbright Scholarship, bringing exceptional students from the US to Ireland.
Scholar Stefan Townes (pictured), a writer from Indiana University Bloomington, explored the literary ties between 20th-century Black America and Ireland. Rebecka Franken, a poet and scholar from Sarah Lawrence College and Brandeis University, focused her research on the Banshee and death messengers in folklore.
This support enriches UCC’s creative community while strengthening its international reputation.

At UCC, we believe education should be a gateway to opportunity for all. For students from underrepresented backgrounds, programmes like HEAR (Higher Education Access Route) and Access UCC PLUS provide vital support, opening doors to university and beyond.
Thanks to these initiatives, and the generosity of philanthropic bursaries, students are empowered to overcome barriers and pursue their dreams. From mentorship in secondary school to financial assistance for postgraduate degrees, these supports are shaping future leaders and ensuring that every student has the chance to fulfil their potential.
One such student is Brian Votta, a Professional Master of Education (PME) candidate at UCC who began his journey at UCC through HEAR and is now a recipient of a bursary funded through Dr Barry Wall’s legacy. After completing his undergraduate degree in History and Geography, with the support of Access UCC’s PLUS Programme, Brian became a mentor himself, working with young students in DEIS schools and inspiring them to pursue further education. “I worked to ignite interest in young people from disadvantaged backgrounds to seek further and higher education,” he says, a mission that aligns directly with the ambition of Dr Barry Wall.
Brian, alongside other scholarship beneficiaries, had the opportunity to share his story at the UCC Benefactors’ Lunch, where he spoke about the transformative impact of philanthropic support. Addressing the attendees, he highlighted how these bursaries not only alleviate financial pressures but also empower students to focus on their studies and future careers, reinforcing the lasting legacy of generosity in higher education.
Now, as a PME student, the bursary has given him the freedom to focus on his studies and teaching placement without the financial burden many aspiring educators face. “It levels the playing field between me and my peers, which I believe is exactly what Dr Barry Wall intended when she established this fund,” Brian reflects.
With Access UCC and the School of Education committed to diversifying Ireland’s teaching workforce, this bursary is more than just financial support, it is a catalyst for change, ensuring that future generations of educators reflect the students they serve.

I’ve
always had a desire to attend a university and eventually become a teacher. Coming from a lower socio-economic background, that goal once seemed uncertain.
”
Brian Votta Recipient of the Dr Mary Barry Wall Bursary
PhD researchers at UCC are tackling some of the world’s most pressing challenges. From sustainability and cancer treatment to Parkinson’s research and creative innovation, donor-funded scholars are driving discoveries with real-world impact. Here, we showcase some of the exceptional PhD students whose work has received support through Cork University Foundation.


The AIB Sustainable Business PhD Scholars programme was established to support early career researchers, who excel in their field, to strengthen sustainable business research in Cork University Business School.
Susana Rivera Gonzalez and Tianning Zhao are two such scholars who are addressing critical issues in sustainability. Their research focuses on topics like renewable energy projects, energy decarbonization and degrowth, working alongside the AIB Professor in Sustainable Business, Valeria Andreoni.
Thanks to the Daniel and Margaret Cronin Advancing Access Scholarships, PhD students at UCC are leading groundbreaking research across medicine, science and the arts.
One PhD candidate’s research focuses on the role of the gut microbiome in Parkinson’s disease, the world’s fastest-growing neurological disorder. Their research explores how gut bacteria influence disease progression and whether certain beneficial compounds could lead to new treatments. By deepening our understanding of the gut-brain connection, this work aims to develop safer, more effective therapies, offering hope for improved quality of life for those living with Parkinson’s.


Dr Robert Hayes recently completed his PhD with the Autophagy team at Cancer Research @UCC, with the aid of philanthropic support from our donors. Robert’s research investigated drug resistance in oesophageal cancers and looked for new ways to target treatment resistant cancers.
“Many oesophageal cancers develop resistance to the drugs currently used to treat this disease. By examining how genes can influence response to treatment and understanding how these genes regulate death and survival in cancer cells, we’ll be able to develop more effective anti-cancer agents for the future” says Robert.

Rishin Singh and Maxine Acton-Carey were both recipients of the Dr Danijela Kulezic-Wilson Memorial Scholarships, established by Doug Murray and the WHH Foundation to support students who embody the late Dr Wilson’s interdisciplinary and groundbreaking spirit.
Maxine Acton-Carey’s PhD explores how teaching drama to medical students can improve communication, empathy, adaptability, and teamwork. By creating and testing a drama module for medical students at UCC, her research aims to make medical education more engaging and help future doctors develop important communication skills.
Through his research, Malaysian composer Rishin Singh will challenge traditional views in opera by exploring ways to break free from outdated stereotypes and focus on multicultural, more meaningful musical experiences.
In a new approach to teaching, Irish law firm McCann FitzGerald LLP together with UCC are jointly delivering a new sustainability-focused curriculum for students at UCC’s School of Law.
This was developed in response to growing regulatory changes and increased demand from businesses for specialist advice in this complex and expanding area of legislation.
Led by Professor Femi Amao, Professor of Company Law & Sustainability, the programme, Environmental, Social & Corporate Governance (ESG) and Businesses: Law, Policy and Practice, has been co-developed and will be co-delivered by the School of Law and McCann FitzGerald LLP, to provide a unique blended learning experience for students from both academics and expert practitioners.
Professor Amao will collaborate with colleagues across the university to advance the sustainable development of business and society, as part of UCC’s wider Futures Sustainability initiative.
McCann FitzGerald LLP partners, including Éamon Ó Cuív, Ciara Ryan, Brendan Slattery and Laura Treacy, will deliver seminars with a specific
practitioner focus, including perspectives on Sustainable Finance, ESG Disputes and Litigation, Sustainability Reporting and ESG considerations for Competition Law.
“
There is a growing need for ongoing education, deeper understanding and further specialism in how sustainability considerations are being integrated into law and public policy.
Éamon Ó Cuív McCann FitzGerald LLP



As part of its wider relationship with UCC School of Law, McCann FitzGerald LLP will continue to support a bursary in first year
Contract Law and prizes for law students at both undergraduate BCL and postgraduate LLB level.
The 2023-2024 academic year saw UCC alumni return to campus for joyful class reunions, rekindling friendships and reminiscing about their student days.
Beyond the laughter and shared memories, many classes chose to give something back. Thank you to those who made personal and class gifts at their reunions to the UCC Alumni Fund and Cancer Research @UCC.
These reunions prove that while time moves on, the UCC spirit of connection and giving remains as strong as ever.
Interested in getting your class back together? Request more information about organising your own class reunion by contacting alumni@ucc.ie



“
I am delighted I travelled from Melbourne to attend. I will treasure the wonderful memories forever.
”
Hugh O’Donnell BComm ‘84


“
It was simply an incredible evening - so much fun meeting our class after so long. Hair had changed somewhat, but the voices were still the same. The stories, the memories, the pictures—all served to melt the 40 years to minutes.
Roger Grufferty BDS ‘84

Thanks to the generosity of our donors, the UCC Remembrance Bench stands as a lasting tribute to alumni, students, and staff who have passed away.
Set along the serene banks of the River Lee at Perrott’s Inch, near the Cavanagh Bridge, the bench provides a peaceful space for reflection, offering comfort to those who wish to honour the memory and legacy of their loved ones.
This special project was made possible through philanthropic support, ensuring that future generations will have a dedicated place to pause, reflect, and celebrate the lives of those who have shaped our university community.
Just as the UCC Remembrance Bench serves as a lasting tribute, leaving a legacy provides an opportunity to make a meaningful and enduring impact on the university. Through bequests and planned giving, alumni, staff, and friends of UCC have played a pivotal role in funding vital initiatives and life-changing scholarships. Their generosity has also fueled groundbreaking research and medical advancements.
Legacy gifts play a crucial role in enhancing student resources and supporting the long-term sustainability of world-class education at UCC. Even modest donations create significant opportunities, enabling students to attend international conferences, engage in transformative learning experiences, and pursue academic excellence.
By choosing to leave a gift, you help preserve UCC’s mission and shape its future—ensuring that generations to come continue to benefit from exceptional learning, research, and global engagement.
For more information on how you can leave a lasting legacy, please contact foundation@ucc.ie


“
I hope that this will be a special place for those in our community to remember a loved one, where they can find comfort and healing. This beautiful new bench will serve as a lasting reminder and celebration of their life here on campus. May all those in our community who have gone before us, Rest in Peace.
”
Professor John O’Halloran President

“
It is a privilege to serve as Chair of CUF, working alongside a dedicated group of volunteers who champion fundraising efforts aligned with our university’s strategic vision.
”
Neil O’ Leary Chair, Cork University Foundation
The Cork University Foundation is incorporated in Ireland as a limited liability company and a registered charity:
Company Registration Number (CRN): 243605
Registered Charity Number (RCN): 20033385
Chartitable Tax Exemption Number: CHY11831
Chair Neil O’Leary
Secretary Nora Geary Corporate Secretary, UCC
Ex Officio
Professor John O’Halloran President, UCC
Directors Maeve Cavanagh O’Shaughnessy (Vice Chair)
John Fitzgerald
David Merriman
Honor Moore
Bill Murphy
Dr Dermot O’Mahoney
Sean Shine
Aidan Synnott
CEO Kerry Bryson CEO, Cork University Foundation Director of Business Development and Advancement, UCC
Independent Auditors
PricewaterhouseCoopers
Chartered Accountants and Statutory Audit Firm,
One Albert Quay, Cork, Ireland
Bankers AIB
66 South Mall, Cork, Ireland
Solicitors RDJ LLP
85 South Mall, Cork, Ireland
UCC’s impactful research, innovative academic programmes and singular student experience all benefit from philanthropic contributions to Cork University Foundation, the charitable arm of UCC. Whether you are an alum, student, staff member, parent, business, non-profit or otherwise, there are many ways that you can support the university.

To make a once off or recurring gift on a debit or credit card online, please visit our secure giving site, alumni.ucc. ie/makeagift

Make a one-time or recurring gift directly from your bank account* to a fund of your choice by direct debit. This is a great way to make monthly, quarterly or annual donations automatically, providing sustained support for UCC. Request a direct debit form by emailing foundation@ucc.ie
*Irishbankaccountsonly

Give by Cheque
Euro: Cheques must be made payable to Cork University Foundation
GBP Sterling: Cheques must be made payable to UCC Educational Foundation
US Dollar: Cheques must be made payable to The Chapel & York US Foundation
Canadian Dollar: Cheques must be made payable to University College Cork
Rest of World: Cheques in other currencies must be made payable to Cork University Foundation
Please send completed cheques to: Advancement Office UCC, 2.12 Western Gateway Building, Western Road, Cork, T12 XF62, Ireland

Many donors are able to take advantage of matching gifts from their employer or their spouse’s employer to double or even triple the impact of their donations to the university. If your company has a matching gift program, please contact foundation@ucc.ie to discuss next steps.

Whether you want to provide scholarships for gifted students, bursaries for disadvantaged students, support ground-breaking research or help fund an academic post, leaving a bequest to UCC is one of most meaningful actions a supporter can take and will make a difference at UCC for generations.

Cork University Foundation accepts donations from wire transfers, donor advised funds, gifts of stock and other sources. To learn more and discuss your options, please contact foundation@ucc.ie
Donors in Ireland can see greater impact from their donations. Cork University Foundation can claim a tax refund of up to 45% from Revenue on donations from supporters who give € 250 or more in a calendar year.

The UCC Donor Charter outlines the university’s stewardship policy and sets out the standards that donors can expect from the Cork University Foundation and UCC. The charter adheres to the tenets of the Donor Bill of Rights, the Charities Act 2009 and the Charities Regulator. Donors have the following rights:
i) All communications made to potential donors concerning a project will be honest, truthful and comply with the law.
ii) The donor’s right to privacy will be respected in accordance with GDPR/data protection legislation.
iii) The CUF/university will not accept an “anonymous” gift over €1000 without the Director of Business Development & Advancement and at least two of the following people (President, Corporate Secretary, the Chief Financial & Operating Officer, Chair of Cork University Foundation or Chair of Governing Authority) being aware of the source of the donation. Donors, who request anonymity, will be respected (i.e. the university will not publish their name on a donor list).
iv) The gift will be acknowledged promptly and applied for the purpose for which it was originally requested, unless explicit written consent is given otherwise by the donor, or, in the case of legacies/ bequests, for the purposes described in the donor’s will or for similar purposes agreed with the individual’s executors.
v) The university/CUF will not normally return a gift which has been accepted in good faith. If a situation arises which gives the need to review a previous decision to accept a gift, the matter will be referred to the President and Chair of Cork University Foundation to agree to the next steps. If, following a conversation, the university cannot honour the terms of the gift, and a compromise cannot be reached with the donor, CUF/the university will refund the gift to the donor, their estate or legal representative as appropriate.
vi) The gift will be handled responsibly, to the greatest advantage of the beneficiary and without disadvantage to the university.
vii) The donor’s personal data will be respected, and there will be transparency in the university’s communications with its donors.
viii) The university/CUF will thank and recognise the donor appropriately, including issuing official gift receipts, gift agreements or other documents where required.
ix) From time to time, the university may offer to recognise a gift or a gift-in-kind by naming the object of the donation (i.e. part or all of a capital project) after the donor. Such offers will be subject to the guidelines of the UCC Naming Policy (currently under review).
x) Adequate records of all gifts will be maintained on the Raisers’ Edge NXT/Advancement database to allow a proper audit trail.
xi) The university will not sell its donor list.
xii) Any concerns raised in relation to the above points will be dealt with swiftly and effectively by the Director of Business Development & Advancement/CEO of Cork University Foundation.
xiii) In addition, a donor will be fully informed of CUF, contact details, charitable status and the identity of those individuals serving on the board. Gifts are subject to an annual audit by a firm of independent auditors. Anyone fundraising on behalf of CUF or UCC will be subject to a written agreement between both parties. If agent fees are to be paid to the third party from the donation this will be declared to the potential donor from the outset.










If you have any queries, or would like to visit campus and learn more about UCC’s funding priorities, please contact us at foundation@ucc.ie
If you have any queries, or would like to visit campus and learn more about UCC’s funding priorities, please contact any member of staff:
Kerry Bryson CEO, Cork University Foundation, and Director of Business Development & Advancement Advancement Office, UCC
Kerry Bryson Director of Business Development and Advancement UCC.
Deirdre Stuart
Cal Healy Director of Development, Alumni and Development, UCC.
Incoming Secretary, Cork University Foundation, and Associate Director of Finance & Operations for Advancement Advancement Office, UCC
Kate McSweeney
Director of Communications, Alumni and Development, UCC.
E: foundation@ucc.ie

Cork University Foundation, University College Cork (RCN No: 20033385)
UCC Educational Foundation (UK), University College Cork (Registration No. 1021681)
c/o Advancement Office (formerly Alumni and Development), University College Cork
2.12 Western Gateway Building | Western Road | Cork | T12 XF62 | Ireland
E: foundation@ucc.ie | T: +353 (0)21 420 5403 | W: https://cufdevelopment.ucc.ie